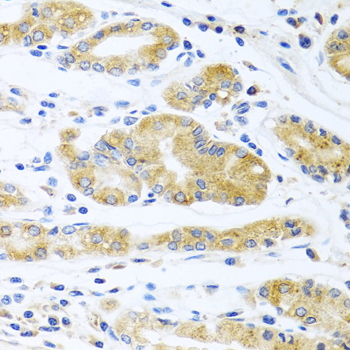

-
Product Name
APOE Polyclonal Antibody
- Documents
-
Description
Polyclonal antibody to APOE
-
Tested applications
WB, IHC, IF
-
Species reactivity
Human, Mouse
-
Alternative names
APOE antibody; AD2 antibody; APO-E antibody; ApoE4 antibody; LDLCQ5 antibody; LPG antibody; apolipoprotein E antibody
-
Isotype
Rabbit IgG
-
Preparation
Antigen: A synthetic peptide corresponding to a sequence within amino acids 200-300 of human APOE (NP_000032.1).
-
Clonality
Polyclonal
-
Formulation
PBS with 0.02% sodium azide, 50% glycerol, pH7.3.
-
Storage instructions
Store at -20℃. Avoid freeze / thaw cycles.
-
Applications
WB 1:500 - 1:2000
IHC 1:50 - 1:200
IF 1:50 - 1:200 -
Validations

Western blot - APOE Polyclonal Antibody
Western blot analysis of extracts of various cell lines, using ApoE antibody at 1:1000 dilution.Secondary antibody: HRP Goat Anti-Rabbit IgG (H+L) at 1:10000 dilution.Lysates/proteins: 25ug per lane.Blocking buffer: 3% nonfat dry milk in TBST.Detection: ECL Basic Kit .Exposure time: 90s.

Immunohistochemistry - APOE Polyclonal Antibody
Immunohistochemistry of paraffin-embedded human prostate using ApoE antibody at dilution of 1:100 (40x lens).
Immunohistochemistry - APOE Polyclonal Antibody
Immunohistochemistry of paraffin-embedded human stomach using ApoE antibody at dilution of 1:100 (40x lens).

Immunohistochemistry - APOE Polyclonal Antibody
Immunohistochemistry of paraffin-embedded mouse lung using ApoE antibody at dilution of 1:100 (40x lens).

Immunofluorescence - APOE Polyclonal Antibody
Immunofluorescence analysis of A431 cells using ApoE antibody at dilution of 1:100 (40x lens). Blue: DAPI for nuclear staining.
-
Background
APOE is an apolipoprotein, a protein associating with lipid particles, that mainly functions in lipoprotein-mediated lipid transport between organs via the plasma and interstitial fluids. APOE is a core component of plasma lipoproteins and is involved in their production, conversion and clearance. Apoliproteins are amphipathic molecules that interact both with lipids of the lipoprotein particle core and the aqueous environment of the plasma. As such, APOE associates with chylomicrons, chylomicron remnants, very low density lipoproteins (VLDL) and intermediate density lipoproteins (IDL) but shows a preferential binding to high-density lipoproteins (HDL). It also binds a wide range of cellular receptors including the LDL receptor/LDLR, the LDL receptor-related proteins LRP1, LRP2 and LRP8 and the very low-density lipoprotein receptor/VLDLR that mediate the cellular uptake of the APOE-containing lipoprotein particles. Finally, APOE has also a heparin-binding activity and binds heparan-sulfate proteoglycans on the surface of cells, a property that supports the capture and the receptor-mediated uptake of APOE-containing lipoproteins by cells. A main function of APOE is to mediate lipoprotein clearance through the uptake of chylomicrons, VLDLs, and HDLs by hepatocytes. APOE is also involved in the biosynthesis by the liver of VLDLs as well as their uptake by peripheral tissues ensuring the delivery of triglycerides and energy storage in muscle, heart and adipose tissues. By participating to the lipoprotein-mediated distribution of lipids among tissues, APOE plays a critical role in plasma and tissues lipid homeostasis. APOE is also involved in two steps of reverse cholesterol transport, the HDLs-mediated transport of cholesterol from peripheral tissues to the liver, and thereby plays an important role in cholesterol homeostasis. First, it is functionally associated with ABCA1 in the biogenesis of HDLs in tissues. Second, it is enriched in circulating HDLs and mediates their uptake by hepatocytes. APOE also plays an important role in lipid transport in the central nervous system, regulating neuron survival and sprouting. APOE in also involved in innate and adaptive immune responses, controlling for instance the survival of myeloid-derived suppressor cells (By similarity). APOE, may also play a role in transcription regulation through a receptor-dependent and cholesterol-independent mechanism, that activates MAP3K12 and a non-canonical MAPK signal transduction pathway that results in enhanced AP-1-mediated transcription of APP.
Related Products / Services
Please note: All products are "FOR RESEARCH USE ONLY AND ARE NOT INTENDED FOR DIAGNOSTIC OR THERAPEUTIC USE"
